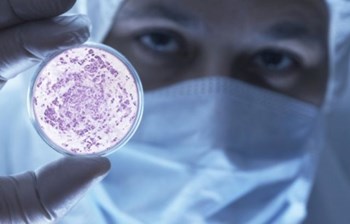

Izbor odgovarajuće ambalaže značajno utiče na nekoliko oblasti poslovanja kompanije: vreme pakovanja, troškove skladištenja, logističke troškove, kvotu reklamacije, a na kraju i na plasiranje vaših proizvoda.
Pametna polietilenska ambalaža kompanije Izoterm-Plama je ekološki prihvatljiva, 100% reciklažna i nudi širok spektar različitih pakovanja, posebno pogodnih za zaštitu osetljivih površina od mehaničkih oštećenja tokom faze proizvodnje ili tokom transporta proizvoda. Pakovanje je lagano, elastično i olakšava upotrebu.
Duga tradicija proizvodnje prema zahtevnim standardima ISO 9001 i ISO 14001 dokazuje vrhunski kvalitet, dok fleksibilnost proizvodnje i širok izbor standardnih artikala na zalihama pružaju brzu i pouzdanu uslugu.
Standardna ambalaža
Plama CELL ambalažna folija od penjenog polietilena je izrađena od ekspandiranog polietilena zatvoreno-ćelijske strukture, koji obezbeđuje izuzetnu zaštitu osetljivih površina od ogrebotina i mehaničkih oštećenja. Folija je lagana, elastična i omogućava jednostavnu primenu. Zatvoreno-ćelijski ekspandirani polietilen je jedan od najčešće upotrebljavanih materijala u pakirnoj industriji i proizveden je bez CFC ili HCFC jedinjenja.
.jpg)
Plama CELL ambalažna folija (Foto: Izoterm-Plama)
Plama BOLL air-bubble film se proizvodi iz slojeva polietilenskih prevlaka niske gustine, može se izrađivati sa antistatik aditivima u cilju zaštite elektro proizvoda ili za potrebe "dust free" primene.
.jpg)
Plama BOLL air-bubble film (Foto: Izoterm-Plama)
Ambalažni profili PlamaPACK izrađeni su od ekspandiranog polietilena zatvoreno-ćelijske strukture. Dostupni su u različitim oblicima što omogućava višenamensku upotrebu ovih profila za pakovanje i zaštitu proizvoda. Proizvodni program Izoterm-Plame se sastoji od profila standardnih oblika, kao što su L i U profili, profila za stakla i drugih specijalnih profila. Osnovni oblici naših profila se mogu preraditi u različite vrste ugaonika i kutnika.
.jpg)
Ambalažni profili PlamaPACK (Foto: Izoterm-Plama)
Tehnička ambalaža
MULTIFOAM je laminirana ploča neumrežene polietilenske pene proizvedena u ISOFOM SRL. Zahvaljujući svojoj karakterističnoj elastičnosti MULTIFOAM je idealan proizvod za sve ambalažne primene u kojima je potrebno postići efekat "zaštitnog jastuka" usled udara koji se ponavljaju. Dostupan je u debljinama od 10 do 120mm i u različitim gustinama. Upotrebom specijalnih aditiva proizvodi se u crnoj i ružičastoj - pink boji (antistatik).
.jpg)
MULTIFOAM laminirana ploča (Foto: Izoterm-Plama)
ET-PLANK je monoekstrudirana ploča od neumrežene polietilenske pene proizvedena u ISFOM SRL. Zahvaljujući svojoj posebnoj zatvoreno-ćelijskoj strukturi, dobijenoj specifičnim proizvodnim procesom, ET-PLANK je idealan proizvod za primenu u slučajevima potrebe amortizacije udara, prigušenja vibracija i efekta "zaštitnog jastuka", posebno za teške proizvode. Dostupan je u debljinama 50 i/ili 100mm i sa gustinama koje se kreću od 220Pcf (35 kg/m3) do 900 Pcf (150 kg/m3). Upotrebom specijalnih aditiva proizvodi se u crnoj (provodna) i ružičastoj - pink boji (antistatik).
.jpg)
ET-PLANK monoekstrudirana ploča (Foto: Izoterm-Plama)
Savremeni pristup i tehnološki napredak
Izoterm-Plama se nalazi među tehnološki najopremljenijim kompanijama iz oblasti PE pene u ovom delu Evrope, što osigurava visokokvalitetne proizvode, optimalnu fleksibilnost proizvodnje i zadovoljstvo kupaca. Proizvodni pristup je unapređen pre nekoliko godina konceptom vitke proizvodnje (Toiotin proizvodni sistem).
Pakovanje prilagođeno vašim potrebama
U saradnji sa klijentima iz raznih grana, u poslednjih nekoliko godina kompanija Izoterm-Plama imala je priliku da razvije ambalažu za razne vrlo zahtevne proizvode prateći principe smanjivanja materijala i vremenskih troškova pakovanja.
Značaj pakovanja:
- zaštita proizvoda u transportu;
- smanjenje troškova reklamacija;
- zaštita između proizvodnih faza;
- smanjenje troškova tehnološkog otpada.
Za više informacija kontaktirajte kompaniju Izoterm-Plama koja se bavi i proizvodnjom izolacionih materijala.

;